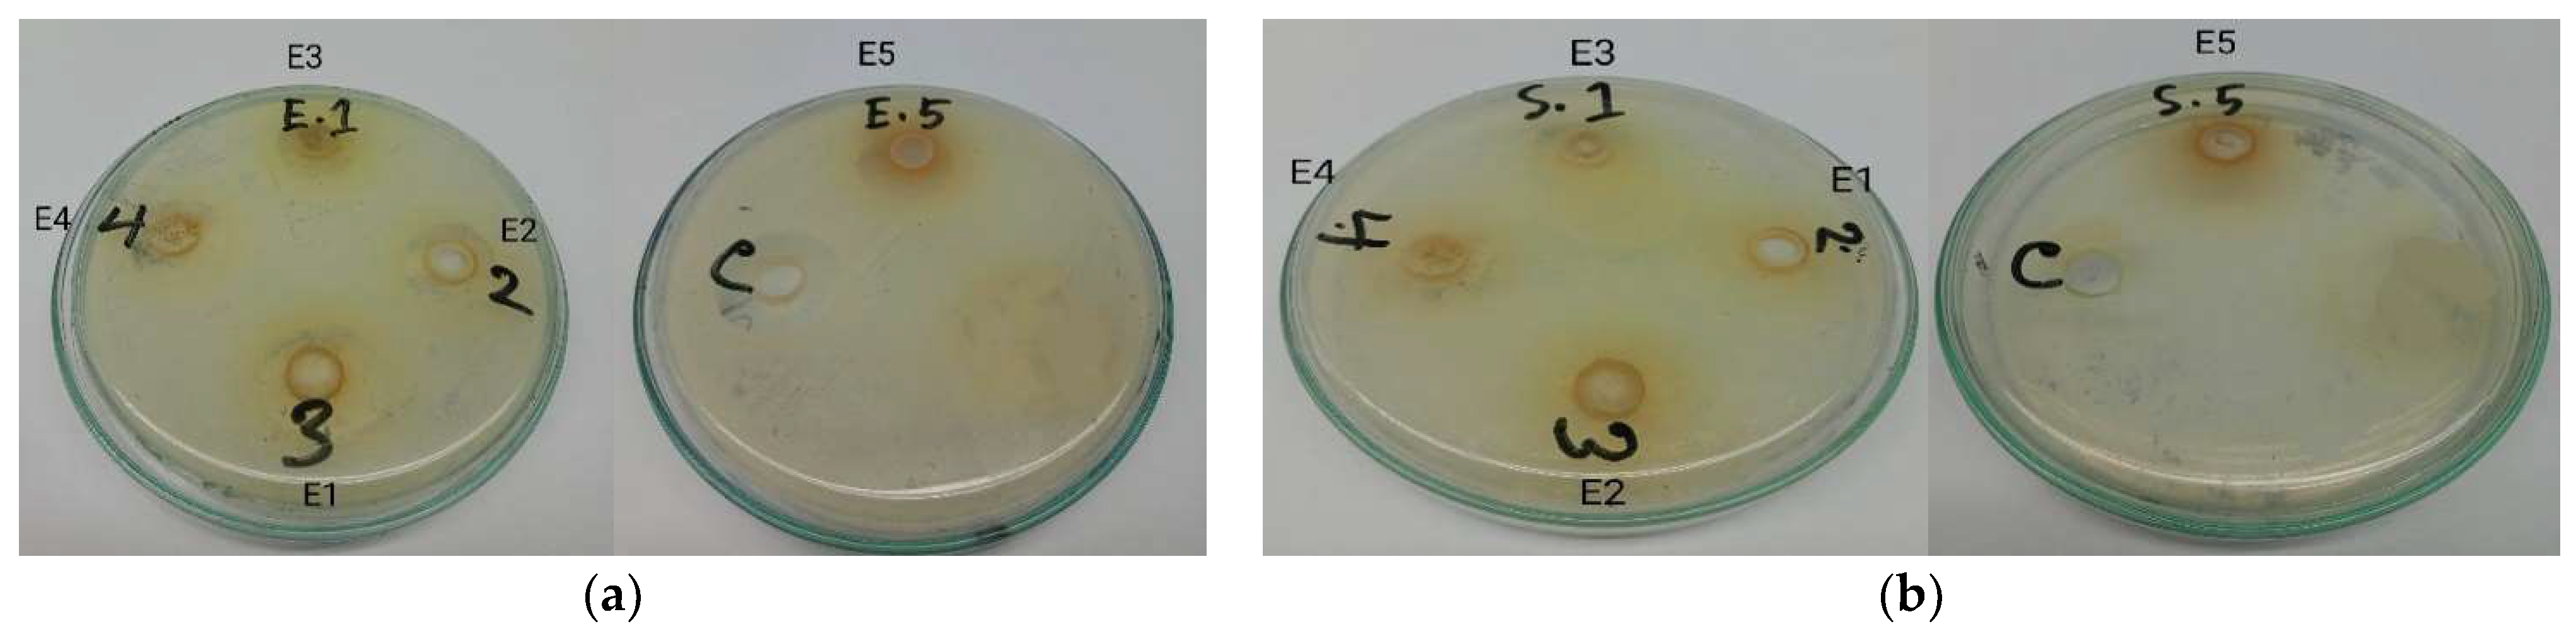
Sustainability 14 15071 g009 Sustainability 14 15071 g009
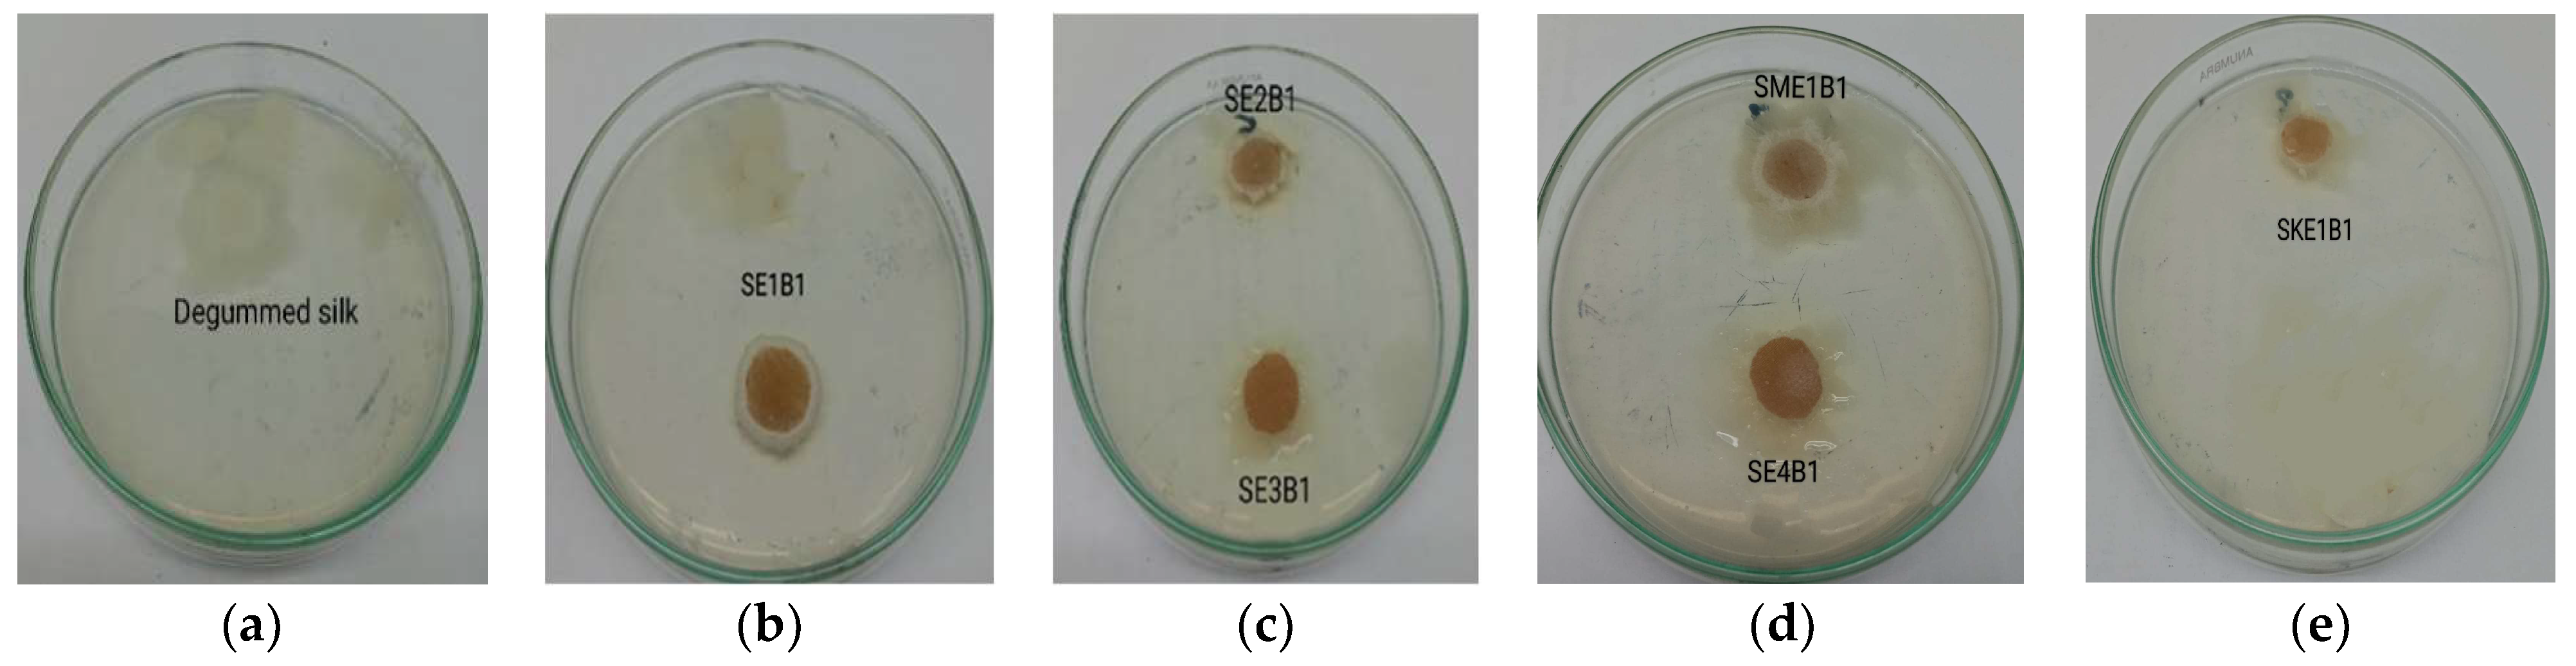
Sustainability 14 15071 g011 Sustainability 14 15071 g011
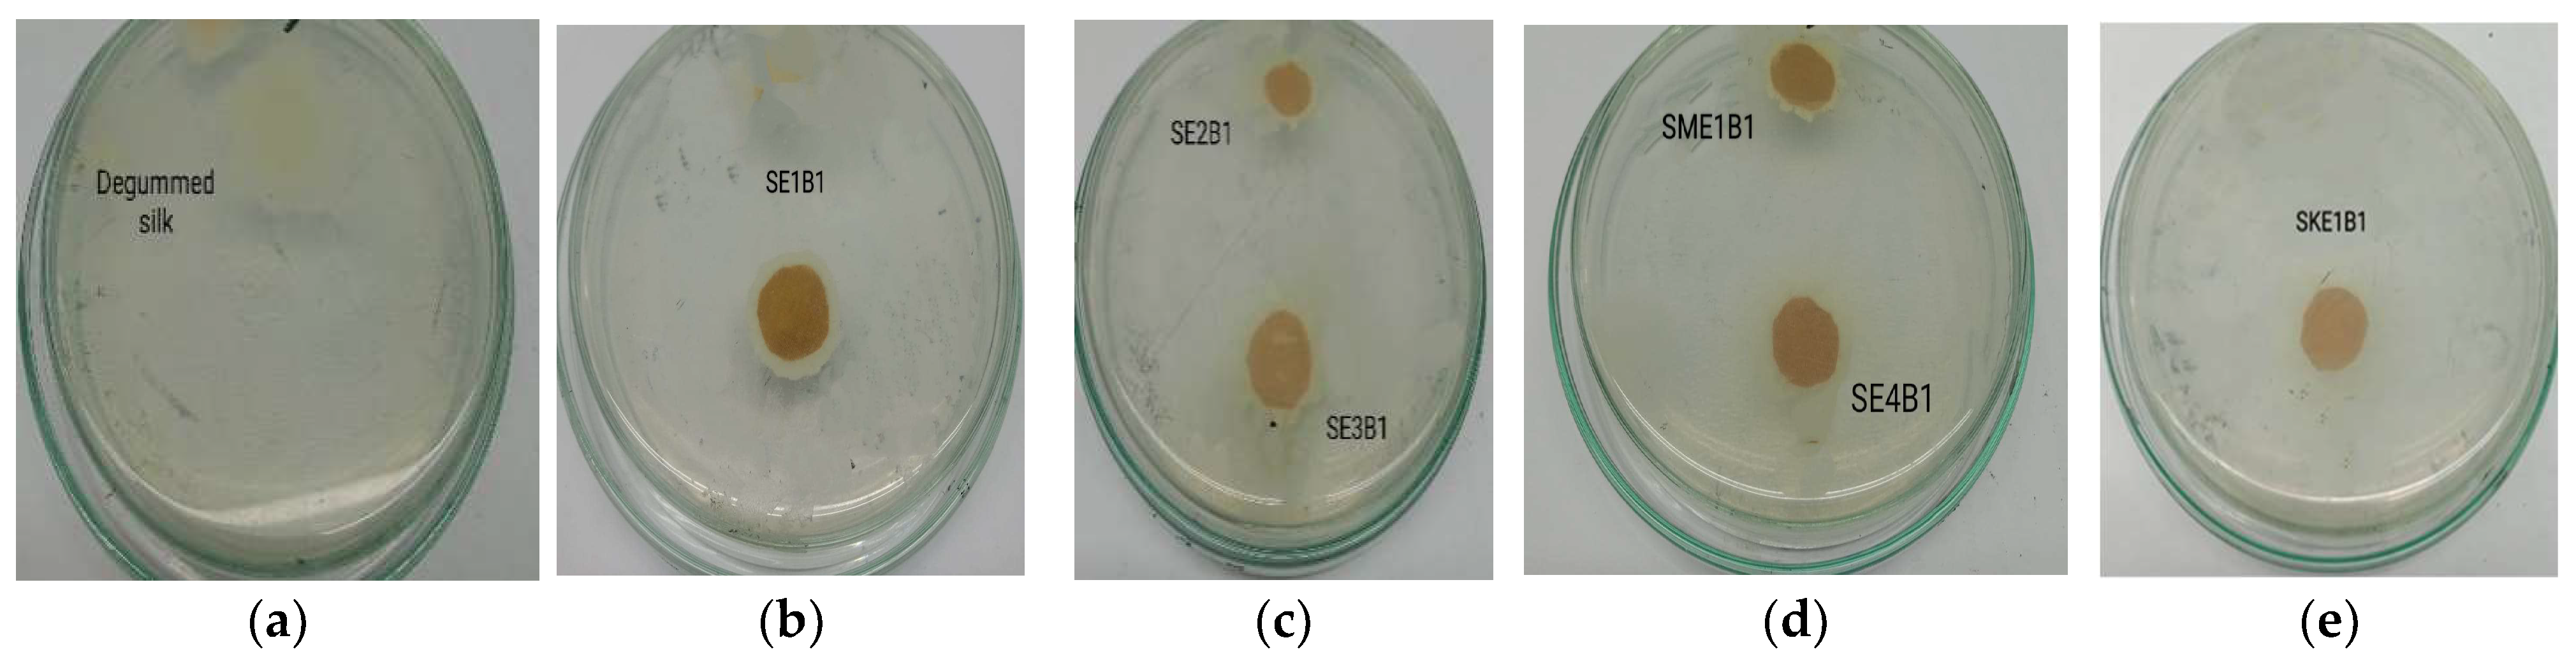
Sustainability 14 15071 g012 Sustainability 14 15071 g012

A Sustainable Approach to Study on Antimicrobial and Mosquito Repellency Properties of Silk Fabric Dyed with Neem (Azadirachta indica) Leaves Extractions
Abstract
1. Introduction
2. Experimental Procedure
2.1. Materials
2.1.1. Fabric
2.1.2. Dye and Mordant
2.2. Methods
2.2.1. Extraction
2.2.2. Dyeing
2.2.3. Sample Labeling
2.3. Characterization
2.3.1. Ultraviolet-Visible (UV-Vis) Spectrophotometry
2.3.2. True-Close Tolerance Spectrophotometer
2.3.3. Colorfastness
2.3.4. Antimicrobial Analysis
2.3.5. Mosquito Repellency Analysis
2.3.6. Allergy Test
2.3.7. Fourier Transform Infrared Spectroscopy (FT-IR)
3. Results and Discussions
3.1. Absorbance of Extracted Solutions
3.2. Color Strength
3.3. Colorfastness
3.4. Antimicrobial Analysis
3.5. Mosquito Repellency Analysis
3.6. Allergy Test Analysis
3.7. FT-IR Test Analysis
4. Conclusions
Supplementary Materials
Author Contributions
Funding
Institutional Review Board Statement
Informed Consent Statement
Data Availability Statement
Acknowledgments
Conflicts of Interest
References
- Datta, R.K.; Nanavaty, M. Global Silk Industry: A Complete Source Book; Universal-Publishers: Irvine, CA, USA, 2005. [Google Scholar]
- Peng, Z.; Yang, X.; Liu, C.; Dong, Z.; Wang, F.; Wang, X.; Hu, W.; Zhang, X.; Zhao, P.; Xia, Q. Structural and mechanical properties of silk from different instars of Bombyx mori. Biomacromolecules 2019, 20, 1203–1216. [Google Scholar] [CrossRef] [PubMed]
- Chen, X.; Hou, D.; Tang, X.; Wang, L. Quantitative physical and handling characteristics of novel antibacterial braided silk suture materials. J. Mech. Behav. Biomed. Mater. 2015, 50, 160–170. [Google Scholar] [CrossRef] [PubMed]
- Alexander, J.W.; Kaplan, J.Z.; Altemeier, W. Role of suture materials in the development of wound infection. Ann. Surg. 1967, 165, 192. [Google Scholar] [CrossRef] [PubMed]
- Zuo, B.; Dai, L.; Wu, Z. Analysis of structure and properties of biodegradable regenerated silk fibroin fibers. J. Mater. Sci. 2006, 41, 3357–3361. [Google Scholar] [CrossRef]
- Andreeßen, C.; Steinbüchel, A. Recent developments in non-biodegradable biopolymers: Precursors, production processes, and future perspectives. Appl. Microbiol. Biotechnol. 2019, 103, 143–157. [Google Scholar] [CrossRef]
- Hashino, T.; Otsuka, K. The rise and fall of industrialization: The case of a silk weaving district in modern Japan. Aust. Econ. Hist. Rev. 2020, 60, 46–72. [Google Scholar] [CrossRef]
- Popescu, A. Considerations upon the trends in the world silk trade. People 2018, 7, 10. [Google Scholar]
- Girish, K.; Shankara, B.S. Neem–a green treasure. Electron. J. Biol. 2008, 4, 102–111. [Google Scholar]
- Conrick, J. Neem: The Ultimate Herb; Lotus Press: Dallas, MI, USA, 2001. [Google Scholar]
- Gowda, M.; Sheetal, A.; Kole, C. The Neem Genome; Springer: Berlin/Heidelberg, Germany, 2019. [Google Scholar]
- Lilot, L.S. The Neem Tree: The Village Pharmacy. Ethnobot. Leafl. 2000, 2000, 9. [Google Scholar]
- Biswas, K.; Chattopadhyay, I.; Banerjee, R.K.; Bandyopadhyay, U. Biological activities and medicinal properties of neem (Azadirachta indica). Curr. Sci. 2002, 82, 1336–1345. [Google Scholar]
- Mahmoud, D.A.; Hassanein, N.M.; Youssef, K.A.; Abou Zeid, M.A. Antifungal activity of different neem leaf extracts and the nimonol against some important human pathogens. Braz. J. Microbiol. 2011, 42, 1007–1016. [Google Scholar] [CrossRef] [PubMed]
- Al-Hashemi, Z.S.S.; Hossain, M.A. Biological activities of different neem leaf crude extracts used locally in Ayurvedic medicine. Pac. Sci. Rev. A Nat. Sci. Eng. 2016, 18, 128–131. [Google Scholar] [CrossRef]
- Teklemedhin, T.; Gopalakrishnan, L. Environmental friendly dyeing of silk fabric with natural dye extracted from Cassia singueana plant. J. Text. Sci. Eng. 2018, 3, 2. [Google Scholar] [CrossRef]
- Saxena, S.; Raja, A. Natural dyes: Sources, chemistry, application and sustainability issues. In Roadmap to Sustainable Textiles and Clothing; Springer: Berlin/Heidelberg, Germany, 2014; pp. 37–80. [Google Scholar]
- Wangatia, L.M.; Tadesse, K.; Moyo, S.; Wangatia, L.M.; Tadesse, K.; Moyo, S. Mango bark mordant for dyeing cotton with natural dye: Fully eco-friendly natural dyeing. Int. J. Text. Sci. 2015, 4, 36–41. [Google Scholar]
- Kumar, R.; Mehta, S.; Pathak, S.R. Bioactive constituents of neem. In Synthesis of Medicinal Agents from Plants; Elsevier: Amsterdam, The Netherlands, 2018; pp. 75–103. [Google Scholar]
- Krishnan, Y.; Wong, N. Cytotoxicity and antimicrobial properties of neem (Azadirachta indica) leaf extracts. Int. J. Pharm. Pharm. Sci. 2015, 7, 179–182. [Google Scholar]
- Susmitha, S.; Vidyamol, K.K.; Ranganayaki, P.; Vijayaragavan, R. Phytochemical extraction and antimicrobial properties of Azadirachta indica (Neem). Glob. J. Pharmacol. 2013, 7, 316–320. [Google Scholar]
- Adeel, S.; Zia, K.M.; Abdullah, M.; Rehman, F.U.; Salman, M.; Zuber, M. Ultrasonic assisted improved extraction and dyeing of mordanted silk fabric using neem bark as source of natural colourant. Nat. Prod. Res. 2019, 33, 2060–2072. [Google Scholar] [CrossRef]
- Zuber, M.; Adeel, S.; Rehman, F.U.; Anjum, F.; Muneer, M.; Abdullah, M.; Zia, K.M. Influence of microwave radiation on dyeing of bio-mordanted silk fabric using neem bark (Azadirachta indica)-based tannin natural dye. J. Nat. Fibers 2019, 17, 1410–1422. [Google Scholar] [CrossRef]
- Sahoo, T.; Dash, S.K.; Das, P. Colouring characteristics of neem (Azadirachta indica) bark dye on silk. Int. J. Agric. Environ. Biotechnol. 2013, 6, 695–702. [Google Scholar] [CrossRef]
- Vankar, P.S.; Shanker, R.; Verma, A. Enzymatic natural dyeing of cotton and silk fabrics without metal mordants. J. Clean. Prod. 2007, 15, 1441–1450. [Google Scholar] [CrossRef]
- Abd El Aty, A.A.; El-Bassyouni, G.T.; Abdel-Zaher, N.A.; Guirguis, O.W. Experimental study on antimicrobial activity of silk fabric treated with natural dye extract from neem (Azadirachta indica) leaves. Fibers Polym. 2018, 19, 1880–1886. [Google Scholar] [CrossRef]
- Tan, Q.-G.; Luo, X.-D. Meliaceous limonoids: Chemistry and biological activities. Chem. Rev. 2011, 111, 7437–7522. [Google Scholar] [CrossRef] [PubMed]
- Jahan, T.; Begum, Z.A.; Sultana, S. Effect of neem oil on some pathogenic bacteria. Bangladesh J. Pharmacol. 2007, 2, 71–72. [Google Scholar] [CrossRef]
- Anuar, A.A.; Yusof, N. Methods of imparting mosquito repellent agents and the assessing mosquito repellency on textile. Fash. Text. 2016, 3, 12. [Google Scholar] [CrossRef]
- Raja, A.S.; Kawlekar, S.; Saxena, S.; Arputharaj, A.; Patil, P.G. Mosquito protective textiles—A review. Int. J. Mosq. Res. 2015, 2, 49–53. [Google Scholar]
- Banupriya, J.; Maheshwari, V. Effects of Mosquito Repellent finishes by Herbal Method on Textiles. Int. J. Pharm. Life Sci. 2013, 4, 3133–3134. [Google Scholar]
- Wannang, N.N.; Ajayi, V.F.; Ior, L.D.; Dapar, L.M.; Okwori, V.A.; Ohemu, T. Mosquito repellant property of Azadirachta indica extract (fruit bark and seed kernel). Sci. Res. J. 2015, 3, 1–4. [Google Scholar]
- Shukla, D.; Wijayapala, S.; Vankar, P.S. Effective mosquito repellent from plant based formulation. Int. J. Mosq. Res. 2018, 5, 19–24. [Google Scholar]
- Gupta, A.; Singh, A. Development of mosquito repellent finished cotton fabric using eco friendly mint. Int. J. Home Sci. 2017, 3, 155–157. [Google Scholar]
- Joshi, M.; Ali, S.W.; Rajendran, S. Antibacterial finishing of polyester/cotton blend fabrics using neem (Azadirachta indica): A natural bioactive agent. J. Appl. Polym. Sci. 2007, 106, 793–800. [Google Scholar] [CrossRef]
- Eid, B.M.; El-Sayed, G.M.; Ibrahim, H.M.; Habib, N.H. Durable antibacterial functionality of cotton/polyester blended fabrics using antibiotic/MONPs composite. Fibers Polym. 2019, 20, 2297–2309. [Google Scholar] [CrossRef]
- Liang, Z.; Zhou, Z.; Li, J.; Zhang, S.; Dong, B.; Zhao, L.; Wu, C.; Yang, H.; Chen, F.; Wang, S. Multi-functional silk fibers/fabrics with a negligible impact on comfortable and wearability properties for fiber bulk. Chem. Eng. J. 2021, 415, 128980. [Google Scholar] [CrossRef]
- Mozumder, S.; Majumder, S. Comparison between cotton and silk fabric dyed with turmeric natural colorant. Daffodil Int. Univ. J. Sci. Technol. 2016, 11, 73. [Google Scholar]
- Sonwalkar, T.N. Handbook of Silk Technology; Taylor & Francis: Abingdon, UK, 1993. [Google Scholar]
- Singhee, D.; Samanta, P. Studies on dyeing process variables for application of Tesu (Butea monosperma) as natural dye on silk fabric. J. Nat. Fibers 2019, 16, 1098–1112. [Google Scholar] [CrossRef]
- Ke, G.; Zhao, Z.; Shuhui, C.; Li, J. Green natural dye from Buddleja officinalis and its ultrasonic dyeing on cotton fabric. Pigment. Resin. Technol. 2021, 51, 110–117. [Google Scholar] [CrossRef]
- Hardesty, J.H.; Attili, B. Spectrophotometry and the Beer-Lambert Law: An important Analytical Technique in Chemistry. Collin College, Department of Chemistry. 2010. Available online: http://vfsilesieux.free.fr/1Seuro/BeerLaw.pdf (accessed on 12 October 2022).
- Yang, L.; Kruse, B. Revised Kubelka–Munk theory. I. Theory and application. JOSA A 2004, 21, 1933–1941. [Google Scholar]
- Pinho, E.; Magalhães, L.; Henriques, M.; Oliveira, R. Antimicrobial activity assessment of textiles: Standard methods comparison. Ann. Microbiol. 2011, 61, 493–498. [Google Scholar] [CrossRef]
- Barnard, D.R.; Bernier, U.R.; Xue, R.; Debboun, M. Standard methods for testing mosquito repellents. In Insect Repellents Principles Methods, Uses; Debboun, M., Frances, S.P., Strickman, D., Eds.; CRC Press: Boca Raton, FL, USA, 2006. [Google Scholar]
- Bano, R. Use of chitosan in mosquito repellent finishing for cotton textiles. J. Text. Sci. Eng. 2014, 4, 1. [Google Scholar]
- Phasomkusolsil, S.; Soonwera, M. Comparative mosquito repellency of essential oils against Aedes aegypti (Linn.), Anopheles dirus (Peyton and Harrison) and Culex quinquefasciatus (Say). Asian Pac. J. Trop. Biomed. 2011, 1, S113–S118. [Google Scholar] [CrossRef]
- Chang, K.S.; Tak, J.H.; Kim, S.I.; Lee, W.J.; Ahn, Y.J. Repellency of Cinnamomum cassia bark compounds and cream containing cassia oil to Aedes aegypti (Diptera: Culicidae) under laboratory and indoor conditions. Pest Manag. Sci. Former. Pestic. Sci. 2006, 62, 1032–1038. [Google Scholar] [CrossRef]
- Patra, A.; Raja, A.; Shah, N. Current developments in (Malaria) mosquito protective methods: A review paper. Int. J. Mosquito Res. 2019, 6, 38–45. [Google Scholar]
- Bukhari, H.; Heba, M.; Khadijah, Q. Eco-friendly dyeing textiles with neem herb for multifunctional fabrics. Part 1: Extraction standardization. Int. J. Tech. Res. App. 2014, 2, 51–55. [Google Scholar]
- Chia, M.A.; Akinsanmi, J.T.; Tanimu, Y.; Ladan, Z. Algicidal effects of aqueous leaf extracts of neem (Azadirachta indica) on Scenedesmus quadricauda (Turp.) de Brébission. Acta Bot. Bras. 2016, 30, 1–8. [Google Scholar] [CrossRef]
- Mohammed, H.A.; al Fadhil, A.O. Antibacterial activity of Azadirachta indica (Neem) leaf extract against bacterial pathogens in Sudan. Afr. J. Med. Sci. 2017, 3, 246–2512. [Google Scholar]
- Win, S.; Ni, K.T. Study on Extraction and Application of Natural Dye from Neem Bark (Melia azadirachta L.). Dagon Univ. Res. J. 2020, 11, 263–269. [Google Scholar]
- Venthodika, A.; Chhikara, N.; Mann, S.; Garg, M.K.; Sofi, S.A.; Panghal, A. Bioactive compounds of Aegle marmelos L.; medicinal values and its food applications: A critical review. Phytother. Res. 2021, 35, 1887–1907. [Google Scholar] [CrossRef]
- Saha, S.; Sadhukhan, P.; Sil, P.C. Mangiferin: A xanthonoid with multipotent anti-inflammatory potential. Biofactors 2016, 42, 459–474. [Google Scholar] [CrossRef]
- Quintana, S.E.; Salas, S.; García-Zapateiro, L.A. Bioactive compounds of mango (Mangifera indica): A review of extraction technologies and chemical constituents. J. Sci. Food Agric. 2021, 101, 6186–6192. [Google Scholar] [CrossRef]
- Sarah, R.; Tabassum, B.; Idrees, N.; Hussain, M.K. Bio-active Compounds Isolated from Neem Tree and Their Applications. In Natural Bio-Active Compounds; Springer: Singapore, 2019; pp. 509–528. [Google Scholar]
- Hemmalakshmi, S.; Priyanga, S.; Devaki, K. Fourier Transform Infra-Red Spectroscopy Analysis of Erythrina variegata L. J. Pharm. Sci. Res. 2017, 9, 2062–2067. [Google Scholar]
- Grdadolnik, J. Saturation effects in FTIR spectroscopy: Intensity of amide I and amide II bands in protein spectra. Acta Chim. Slov. 2003, 50, 777–788. [Google Scholar]
- Ţucureanu, V.; Matei, A.; Avram, A.M. FTIR spectroscopy for carbon family study. Crit. Rev. Anal. Chem. 2016, 46, 502–520. [Google Scholar] [CrossRef] [PubMed]
- Ragavendran, P.; Sophia, D.; Arul Raj, C.; Gopalakrishnan, V.K. Functional group analysis of various extracts of Aerva lanata (L.;) by FTIR spectrum. Pharmacologyonline 2011, 1, 358–364. [Google Scholar]
- Fan, L.; Ziegler, T. Application of density functional theory to infrared absorption intensity calculations on main group molecules. J. Chem. Phys. 1992, 96, 9005–9012. [Google Scholar] [CrossRef]
- Ling, S.; Qi, Z.; Knight, D.P.; Shao, Z.; Chen, X. Synchrotron FTIR microspectroscopy of single natural silk fibers. Biomacromolecules 2011, 12, 3344–3349. [Google Scholar] [CrossRef]
- Boulet-Audet, M.; Lefèvre, T.; Buffeteau, T.; Pézolet, M. Attenuated total reflection infrared spectroscopy: An efficient technique to quantitatively determine the orientation and conformation of proteins in single silk fibers. Appl. Spectrosc. 2008, 62, 956–962. [Google Scholar] [CrossRef]
- Devi, D.; Sarma, N.S.; Talukdar, B.; Chetri, P.; Baruah, K.C.; Dass, N.N. Study of the structure of degummed Antheraea assamensis (muga) silk fibre. J. Text. Inst. 2011, 102, 527–533. [Google Scholar] [CrossRef]
- Kong, X.D.; Cui, F.Z.; Wang, X.M.; Zhang, M.; Zhang, W. Silk fibroin regulated mineralization of hydroxyapatite nanocrystals. J. Cryst. Growth 2004, 270, 197–202. [Google Scholar] [CrossRef]
- Kumar, S.; Pandey, A.K. Chemistry and biological activities of flavonoids: An overview. Sci. World J. 2013, 2013, 162750. [Google Scholar] [CrossRef]
- Tundis, R.; Loizzo, M.R.; Menichini, F. An overview on chemical aspects and potential health benefits of limonoids and their derivatives. Crit. Rev. Food Sci. Nutr. 2014, 54, 225–250. [Google Scholar] [CrossRef]

| Extraction | Wavelength λmax (nm) | |||||
|---|---|---|---|---|---|---|
| 300 nm | 370 nm | 430 nm | 490 nm | 510 nm | 620 nm | |
| E1 | 5.49 | 5.61 | 6.44 | 7.73 | 6.78 | 2.96 |
| E2 | 5.37 | 5.29 | 6.21 | 5.51 | 4.97 | 2.01 |
| E3 | 4.89 | 5.05 | 4.89 | 3.23 | 2.66 | 1.97 |
| E4 | 5.21 | 4.86 | 3.19 | 2.48 | 1.58 | 1.06 |
| Extraction | Wavelength, λmax (nm) | Absorbance |
|---|---|---|
| E5 | 430 | 6.22 |
| 500 | 7.95 | |
| 540 | 6.84 |
| Sample | K/S | Sample | K/S | Sample | K/S |
|---|---|---|---|---|---|
| SE1B1 | 13.2 | SKE1B1 | 13.8 | SME1B1 | 11.7 |
| SE1B2 | 12.4 | SKE1B2 | 12.7 | SME1B2 | 10.6 |
| SE1B3 | 11.8 | SKE1B3 | 11.6 | SME1B3 | 9.6 |
| SE2B1 | 12.1 | SKE2B1 | 12.4 | SME2B1 | 10.5 |
| SE2B2 | 11.7 | SKE2B2 | 11.3 | SME2B2 | 9.7 |
| SE2B3 | 11.22 | SKE2B3 | 11.1 | SME2B3 | 9.2 |
| SE3B1 | 11.8 | SKE3B1 | 12.2 | SME3B1 | 8.4 |
| SE3B2 | 11.41 | SKE3B2 | 11.4 | SME3B2 | 8.2 |
| SE3B3 | 9.7 | SKE3B3 | 10.1 | SME3B3 | 8.1 |
| SE4B1 | 11.14 | SKE4B1 | 10.2 | SME4B1 | 8.6 |
| SE4B2 | 11.12 | SKE4B2 | 9.87 | SME4B2 | 8.1 |
| SE4B3 | 10.2 | SKE4B3 | 9.85 | SME4B3 | 7.4 |
| Samples | Dry Rubbing | Wet Rubbing |
|---|---|---|
| SE1B1 | 4/5 | 4 |
| SE2B1 | 4/5 | 4 |
| SE3B1 | 4/5 | 4 |
| SE4B1 | 4/5 | 4 |
| SKE1B1 | 3/4 | 3 |
| SME1B1 | 4/5 | 4 |
| Sample | Color Change | Color Staining | |||||
|---|---|---|---|---|---|---|---|
| Acetate | Cotton | Nylon | Polyester | Acrylic | Wool | ||
| SE1B1 | 4 | 4 | 4 | 4 | 4 | 4 | 4 |
| SE2B1 | 4 | 4 | 4 | 4 | 4 | 4 | 4 |
| SE3B1 | 4/5 | 4/5 | 4/5 | 4 | 4/5 | 4 | 4 |
| SE4B1 | 4 | 4 | 4 | 4/5 | 4 | 4 | 4 |
| SKE1B1 | 3/4 | 3/4 | 3/4 | 3/4 | 3/4 | 3/4 | 3/4 |
| SME1B1 | 4 | 4 | 4 | 4 | 4/5 | 4 | 4 |
| Sample | Color Change | Color Staining | |||||
|---|---|---|---|---|---|---|---|
| Acetate | Cotton | Nylon | Polyester | Acrylic | Wool | ||
| SE1B1 | 4/5 | 4/5 | 4 | 4.5 | 4/5 | 4 | 4/5 |
| SE2B1 | 4 | 4 | 4 | 4 | 4.5 | 4 | 4 |
| SE3B1 | 4 | 4 | 4 | 4.5 | 4 | 4 | 4 |
| SE4B1 | 4 | 4 | 4 | 4 | 4 | 4 | 4 |
| SKE1B1 | 3/4 | 3/4 | 4 | 3/4 | 3/4 | 4 | 4 |
| SME1B1 | 4 | 4 | 4 | 4 | 4 | 4 | 4 |
| Sample | Color Change | Color Staining | |||||
|---|---|---|---|---|---|---|---|
| Acetate | Cotton | Nylon | Polyester | Acrylic | Wool | ||
| SE1B1 | 4 | 4 | 4 | 4 | 4 | 4 | 4 |
| SE2B1 | 4/5 | 4 | 4/5 | 4 | 4 | 4/5 | 4 |
| SE3B1 | 4.5 | 4/5 | 4 | 4/5 | 4 | 4 | 4 |
| SE4B1 | 4 | 4/5 | 4 | 4 | 4 | 4 | 4 |
| SKE1B1 | 4 | 4 | 4 | 4 | 4/5 | 4 | 4 |
| SME1B1 | 4 | 4 | 4 | 4 | 4/5 | 4 | 4 |
| Sample | Color Change | Color Staining | |||||
|---|---|---|---|---|---|---|---|
| Acetate | Cotton | Nylon | Polyester | Acrylic | Wool | ||
| SE1B1 | 4 | 4 | 4.5 | 4 | 4 | 4 | 4 |
| SE2B1 | 4 | 4 | 4 | 4 | 4 | 4 | 4 |
| SE3B1 | 4/5 | 4 | 4.5 | 4 | 4/5 | 4 | 4 |
| SE4B1 | 4/5 | 4/5 | 4 | 4 | 4/5 | 4 | 4 |
| SKE1B1 | 4 | 3/4 | 3/4 | 4 | 3/4 | 4 | 4 |
| SME1B1 | 4 | 4 | 4 | 4 | 4 | 4 | 4 |
| Sample | Color Change |
|---|---|
| SE1B1 | 4 |
| SE2B1 | 4 |
| SE3B1 | 4 |
| SE4B1 | 4 |
| SKE1B1 | 3/4 |
| SME1B1 | 4 |
| Sample | Bacteria Strain (Escherichia coli) Diameter of Inhibition Zone (ZOI) in mm | Bacteria Strain (Staphylococcus aureus) Diameter of Inhibition Zone (ZOI) in mm |
|---|---|---|
| Degummed silk (undyed) | nil | nil |
| SE1B1 | 0.65 | 0.52 |
| SE1B2 | 0.3 | 0.15 |
| SE2B1 | 0.32 | 0.2 |
| SE2B2 | 0.1 | 0.05 |
| SE3B1 | 0.25 | 0.15 |
| SE3B2 | nil | nil |
| SE4B1 | 0.2 | 0.1 |
| SE4B2 | nil | nil |
| SKE1B1 | 0.05 | nil |
| SKE1B2 | nil | nil |
| SME1B1 | 0.67 | 0.53 |
| SME1B2 | 0.34 | 0.25 |
| Sample | U | T | |
|---|---|---|---|
| SE1B1 | 3 | 1 | 66.67 |
| SE1B2 | 5 | 2 | 60 |
| SE2B1 | 5 | 2 | 60 |
| SE2B2 | 5 | 3 | 40 |
| SE3B1 | 6 | 3 | 50 |
| SE3B2 | 5 | 3 | 40 |
| SE4B1 | 4 | 2 | 50 |
| SE4B2 | 4 | 3 | 25 |
| SKE1B1 | 3 | 2 | 33.33 |
| SKE1B2 | 4 | 3 | 25 |
| SME1B1 | 4 | 1 | 75 |
| SME1B2 | 3 | 1 | 66.67 |
| Age Group | Number of Samples (Person) | Allergic Reaction (Observation) |
|---|---|---|
| Teenager (13–19 years) | 01 | No symptom |
| Adulthood (18–35 years) | 01 | No symptom |
| Older adulthood (56-older) | 01 | No symptom |
Publisher’s Note: MDPI stays neutral with regard to jurisdictional claims in published maps and institutional affiliations. |
© 2022 by the authors. Licensee MDPI, Basel, Switzerland. This article is an open access article distributed under the terms and conditions of the Creative Commons Attribution (CC BY) license (https://creativecommons.org/licenses/by/4.0/).
Share and Cite
Jahan, N.; Arju, S.N. A Sustainable Approach to Study on Antimicrobial and Mosquito Repellency Properties of Silk Fabric Dyed with Neem (Azadirachta indica) Leaves Extractions. Sustainability 2022, 14, 15071. https://doi.org/10.3390/su142215071
Jahan N, Arju SN. A Sustainable Approach to Study on Antimicrobial and Mosquito Repellency Properties of Silk Fabric Dyed with Neem (Azadirachta indica) Leaves Extractions. Sustainability. 2022; 14(22):15071. https://doi.org/10.3390/su142215071
Chicago/Turabian StyleJahan, Nusrat, and Sharfun Nahar Arju. 2022. "A Sustainable Approach to Study on Antimicrobial and Mosquito Repellency Properties of Silk Fabric Dyed with Neem (Azadirachta indica) Leaves Extractions" Sustainability 14, no. 22: 15071. https://doi.org/10.3390/su142215071
APA StyleJahan, N., & Arju, S. N. (2022). A Sustainable Approach to Study on Antimicrobial and Mosquito Repellency Properties of Silk Fabric Dyed with Neem (Azadirachta indica) Leaves Extractions. Sustainability, 14(22), 15071. https://doi.org/10.3390/su142215071

